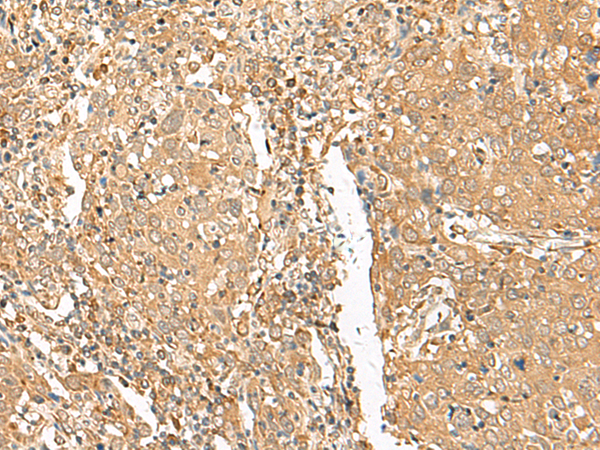

|
Background: |
The Golgi apparatus, which participates in glycosylation and transport of proteins and lipids in the secretory pathway, consists of a series of stacked cisternae (flattened membrane sacs). Interactions between the Golgi and microtubules are thought to be important for the reorganization of the Golgi after it fragments during mitosis. The protein encoded by this gene is a member of the golgin family of proteins, whose members localize to the Golgi. This gene is found in a large, low copy repeat sequence or duplicon that is found in multiple copies, that are greather than 90% similar, on chromosome 15. Duplicons are associated with deletions, inversions and other chromosome rearrangements that underlie genomic disease. The protein encoded by this gene is thought to be a functional golgin protein while the majority of the related copies of this gene are thought to be transcribed pseudogenes. |
|
Applications: |
ELISA, IHC |
|
Name of antibody: |
GOLGA6A |
|
Immunogen: |
Synthetic peptide of human GOLGA6A |
|
Full name: |
golgin A6 family member A |
|
Synonyms: |
GLP; GOLGA6 |
|
SwissProt: |
Q9NYA3 |
|
ELISA Recommended dilution: |
5000-10000 |
|
IHC positive control: |
Human cervical cancer and Human colorectal cancer |
|
IHC Recommend dilution: |
50-300 |

購物車
購物車 幫助
幫助
 021-54845833/15800441009
021-54845833/15800441009
